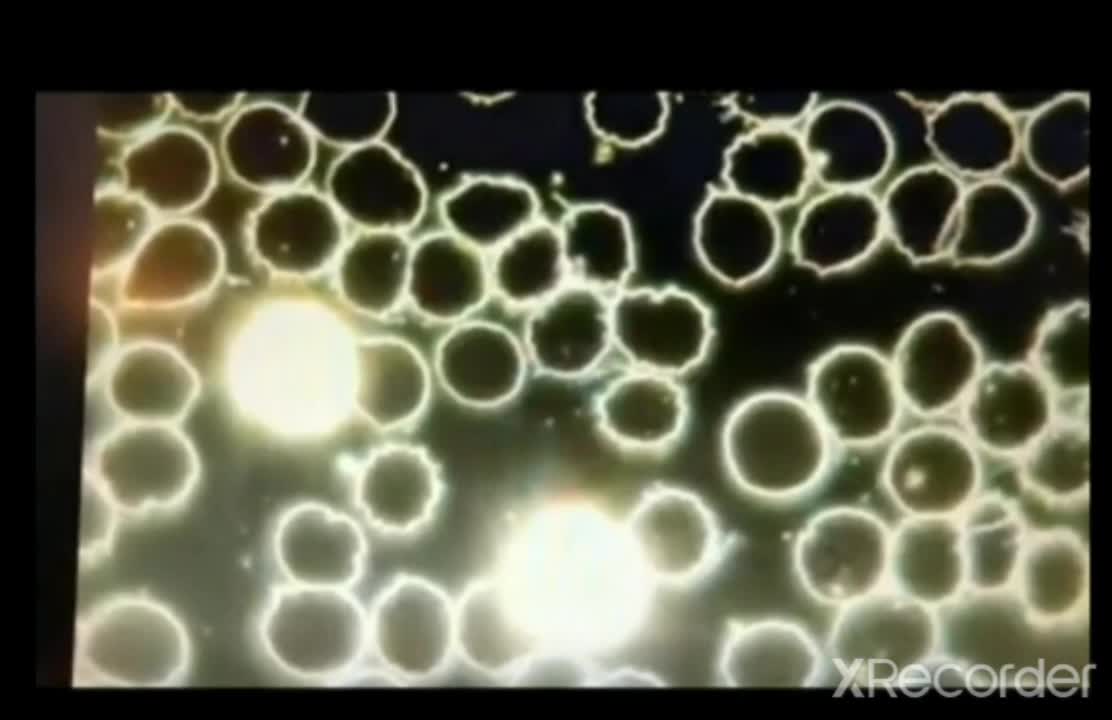

Premium Only Content
This video is only available to Rumble Premium subscribers. Subscribe to
enjoy exclusive content and ad-free viewing.
3차접종 혈액 암시야 현미경 (기생충)
Loading 1 comment...
-
 2:55:43
2:55:43
FreshandFit
13 hours agoLarry Wheels Wife... A Real One or Not?
70K3 -
 1:15:27
1:15:27
Inverted World Live
12 hours agoEpstein’s Blood Experiments, Trump’s UFO Speech, and the 9th Circle of Hell | Ep. 170
118K23 -
 2:52:40
2:52:40
TimcastIRL
9 hours agoIT WAS A HOAX | Timcast IRL #1446
266K100 -
 2:31:41
2:31:41
Decoy
10 hours agoHe's cooked now
127K16 -
 1:01:19
1:01:19
Isabella Moody
12 hours agoINSIDE SCOOP: Meeting Clavicular + Updates With His ARREST In AZ
40.8K4 -
 2:06:26
2:06:26
DLDAfterDark
7 hours ago $4.09 earnedGUN CONTROL Is To Keep You Safe from Criminals Right?? Gun Talk
48.4K8 -
 9:12
9:12
Nicholas Bowling
14 hours ago $2.65 earnedPreacher Gets MOBBED in Front of POLICE at Pride Festival!
42K35 -
 1:04:12
1:04:12
Katie Miller Pod
15 hours ago $18.20 earnedJoe & Tayler Lonsdale on Tech Investments, Life in Texas, & Homeschooling | KMP Ep. 26
180K18 -
 20:07
20:07
Jasmin Laine
9 hours agoTrump Puts Carney on NOTICE—Stalling for a Majority Just Backfired BADLY
45K42 -
 1:28:07
1:28:07
Flyover Conservatives
12 hours agoThey’ve Been Running the World Since WWII (And You Were Never Told) - Mel K | FOC Show
44K6